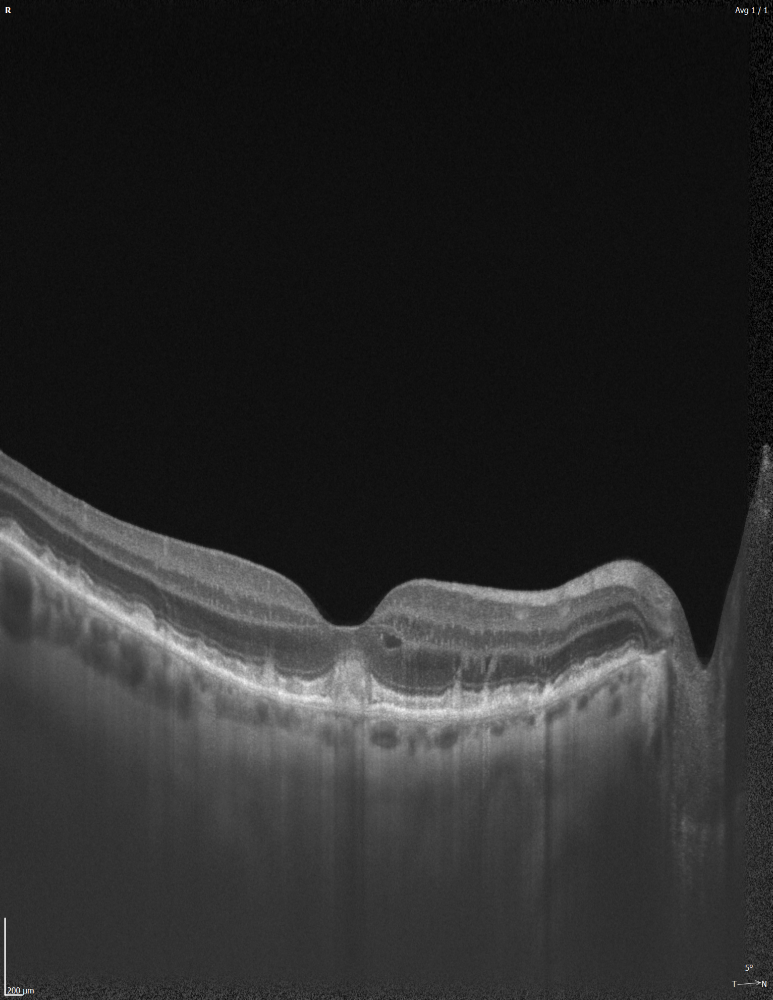

Tomographe à cohérence optique et fond d'œil couleur REVO HR
La combinaison d'une numérisation ultra-rapide à 130 000 balayages par seconde et d'une haute résolution de 3 µm pour des analyses encore plus fines et l'amélioration de la détection des plus petites lésions dans les tissus.
L'OCT REVO HR est un appareil tout-en-un que vous pouvez utiliser de plusieurs façons, comme une caméra de fond d’œil couleur ou en combo, fournissant des images OCT et du fond d’œil simultanées pour une imagerie OCT et OCT-A de très haute qualité.
L'OCT REVO HR est entièrement automatisé, sûr et facile à utiliser.
- La capture d'image couleur haute définition du fond d'œil est possible avec une pupille aussi petite que 3,3 mm.
- Des outils de traitement d'image de fond d'œil faciles à utiliser fournissent une image rétinienne époustouflante.
- Les modes disponibles fournissent des photos détaillées d'un ou des deux yeux, ainsi qu'une comparaison chronologique de la photo du fond d'œil.
- Associez une seule photo du fond d'œil à plusieurs scans OCT.
- Les paramètres d'aperçu du fond d'œil IR et de capture de photo sont ajustés automatiquement en fonction de l'aperçu du fond d'œil IR.
- Pour répondre aux exigences des programmes de dépistage et permettre à l'utilisateur de passer des examens des deux yeux en mode non mydriatique, l'appareil dispose désormais de trois niveaux de flash automatique.
Retina B-scan Vue unique
L'OCT REVO HR est un appareil tout-en-un que vous pouvez utiliser de plusieurs façons :
- En tant que caméra fond d'œil couleur ;
- En tant que combo fournissant des images OCT et du fond d'œil simultanées de très haute résolution ;
- Avec des captures Full Range er Ultra Grand Champ ;
- Pour une imagerie OCT de haute qualité en toutes circonstances avec son mode cataracte, y compris OCT-A ;
- Comme appareil de biométrie et topographe.
L’appareil offre tous les avantages éprouvés des générations précédentes d’appareils OCT spectraux, avec l’ajout d’une caméra de fond d’oeil couleur de pointe pour un nouveau niveau de certitude diagnostique.
La nouvelle version SOCT 21.0 apporte :
- Des algorithmes de segmentation améliorés ;


- Le module Ultra grand champ ;
- Le module de Gestion de la myopie ;
- Le mode Cataracte.
Ce qui rend le REVO HR vraiment unique,
Ce sont ces tomographies OCT de très haute définition et des analyses complètes des couches rétiniennes, du segment antérieur, combinées à une imagerie du fond d’œil rendant l’examen plus polyvalent que jamais. L'OCT REVO HR offre une caméra de fond d’œil non mydriatique intégrée de 12,3 MP capable de capturer des images couleurs détaillées et de très haute qualité
LA CAMÉRA FOND D'ŒIL
Une caméra couleur de 12,3 MP est intégrée à notre appareil All in One OCT capable de capturer des images couleurs détaillées de très haute qualité.
LA TOMOGRAPHIE À COHÉRENCE OPTIQUE
L'OCT REVO HR avec une vitesse de balayage de 130 000 A-scan/sec utilise des technologies de pointe et offre une remarquable simplicité d'utilisation. Il répond à toutes les exigences d'un OCT moderne.

DES TECHNOLOGIES BREVETÉES
ACCUTRACK : suivi oculaire matériel en temps réel.
L'OCT REVO HR est désormais doté d'une fonction de suivi oculaire matériel en temps réel qui compense les clignements, la perte de fixation et les mouvements oculaires involontaires pendant le balayage OCT.
La fonction iTracking est toujours disponible et s'avère utile lors de l'examen de patients qui ont du mal à maintenir la fixation.
AI DENOISE
Amélioration de la qualité des tomographies grâce à l'intelligence artificielle. Les algorithmes d'IA avancés améliorent la qualité d'un seul tomogramme au niveau d'un tomogramme moyen obtenu par plusieurs scans. L'algorithme AI DeNoise filtre le bruit du tomogramme pour une qualité d'image optimale et fluide. La fonction est disponible sur tous les tomogrammes et dans tous les onglets les présentant, y compris l'onglet 3D. Sur les tomographies moyennes, la fonction est activée par défaut. Au moment où un tomogramme est chargé pour examen, le logiciel commence à le débruiter. Après un court instant, le tomogramme original "sans bruit" est remplacé par une image sans bruit.
LE NOUVEAU LOGICIEL EXTENDED DEPTH ET LES CAPTURES FULL RANGE
Avec des scans présentant le nouveau logiciel Extended Depth, basé sur notre technologie Full Range, fournit des scans d'une profondeur accrue pour une observation fiable et pratique des cas difficiles. Avec des scans présentant une profondeur étendue, ce nouveau mode d'imagerie est parfait pour diagnostiquer même les patients très myopes.

LES FONCTIONNALITÉES INCONTOURNABLES
- Analyse Rétine.

- Analyse Chambre Antérieure.




- Acquisitions Ultra grand champ.
 1C 2k (celownik)_1000.jpeg)


- Mode Cataracte.

- Glaucome : Structure et Fonction pour la combinaison des résultats du REVO HR et du champ visuel PTS.

- Suivi d’analyses.



- Angiographie OCT avec fonction panoramique : ce module permet de visualiser la microvascularisation rétinienne. L'angiographie SOCT est une technique non invasive et sans colorant fournissant une image 3D de la circulation sanguine rétinienne.

- Biométrie OCT : B-OCT® est une méthode innovante d'utilisation du dispositif OCT postérieur pour mesurer la structure oculaire le long de l'axe de l'œil. Un calculateur IOL est également disponible.

- Suivi de Myopie forte.

- Topographie OCT : le module Topographie OCT fournit l'analyse des deux surfaces en fonction de la courbure cornéenne, de la puissance dioptrique, de l'élévation et de l'analyse de la puissance réelle en fonction des surfaces et de l'épaisseur locale de la cornée (Ray tracing).


